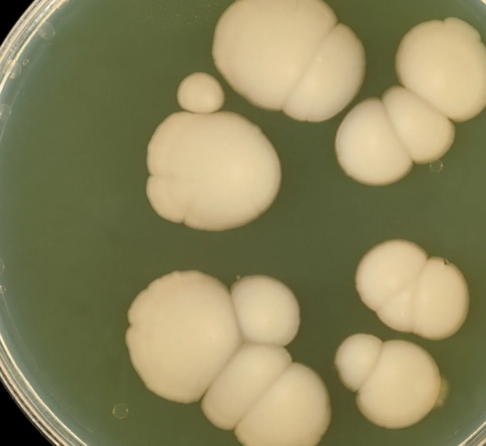
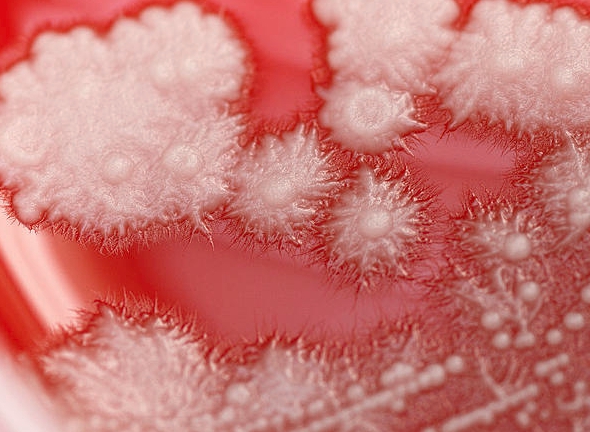

본 블로그의 글에 제휴마케팅이 포함되어 일정 수수료를 제공받을 수 있습니다

칸디다 질염은 칸디다 알비칸스(Candida albicans)라는 곰팡이에 의해 발생하는 질염입니다. 이 곰팡이는 정상적으로 질 내에 존재하지만, 특정 조건에서 과도하게 증식하여 감염을 일으킵니다.
칸디다 질염은 여성에게 매우 흔한 질염 유형 중 하나입니다. 이번 글에서는 칸디다 질염의 주요 증상과 원인에 대해 알아보겠습니다.



질염의 종류 및 원인
질염은 세균성 질염, 칸디다질염, 트리코모나스 질염, 비감염성 질염 등 여러 질염이 있습니다. 자세한 정보는 아래 글에 잘 정리되어 있으니 확인해보시기 바랍니다.
칸디다 질염의 주요 증상
칸디다 질염의 증상은 다음과 같습니다:
1. 가려움
질과 외음부에 심한 가려움증이 나타날 수 있습니다. 이는 칸디다 감염으로 인한 염증 반응 때문입니다.
2. 분비물 변화
흰색 또는 크림색의 두껍고 덩어리진 분비물이 나타날 수 있습니다. 이러한 분비물은 일반적으로 무취이지만, 일부 경우 약간의 냄새가 날 수 있습니다.



3. 붓기 및 발적
질과 외음부가 붓고 붉어질 수 있습니다. 이는 염증으로 인한 반응입니다.
4. 통증
성교 중 또는 배뇨 시 통증을 느낄 수 있습니다. 이는 질과 외음부의 염증으로 인한 자극 때문입니다.
5. 열감
일부 여성은 질과 외음부에 열감을 느낄 수 있습니다. 이는 염증으로 인한 증상 중 하나입니다.

칸디다 질염의 원인
칸디다 질염은 여러 가지 요인에 의해 유발될 수 있습니다. 주요 원인은 다음과 같습니다
1. 항생제 사용
항생제는 몸 안의 유익한 박테리아를 죽여 균형을 깨뜨릴 수 있습니다. 이는 칸디다의 과도한 증식을 초래할 수 있습니다.
2. 면역력 저하
면역 체계가 약해지면 칸디다 감염에 더 취약해질 수 있습니다. 면역억제제를 복용하거나, 당뇨병과 같은 만성 질환이 있는 경우 특히 주의가 필요합니다.

3. 고당분 식단
고당분 식단은 칸디다의 성장을 촉진할 수 있습니다. 설탕이 많은 음식은 피하는 것이 좋습니다.
4. 호르몬 변화
임신, 출산, 폐경 등으로 인한 호르몬 변화는 질 내 환경을 변화시켜 칸디다 감염을 유발할 수 있습니다.
5. 스트레스
스트레스는 면역력을 저하시켜 칸디다 감염의 위험을 증가시킬 수 있습니다.



예방 및 관리 방법
- 적절한 위생 관리: 질 내 세균 균형을 유지하기 위해 향이 없는 비누를 사용하고, 성교 후에는 반드시 청결을 유지합니다.
- 항생제 사용 자제: 항생제는 꼭 필요한 경우에만 사용하고, 사용 후에는 프로바이오틱스를 섭취하여 유익한 박테리아를 회복합니다.
- 건강한 식단: 고당분 음식을 피하고, 균형 잡힌 식사를 통해 면역력을 유지합니다.
- 스트레스 관리: 스트레스를 줄이기 위한 생활습관 개선이 필요합니다.
칸디다 질염은 흔한 질염 중 하나이지만, 적절한 예방과 관리로 증상을 완화할 수 있습니다. 증상이 나타나면 전문가의 상담을 받아 적절한 치료를 받는 것이 중요합니다.